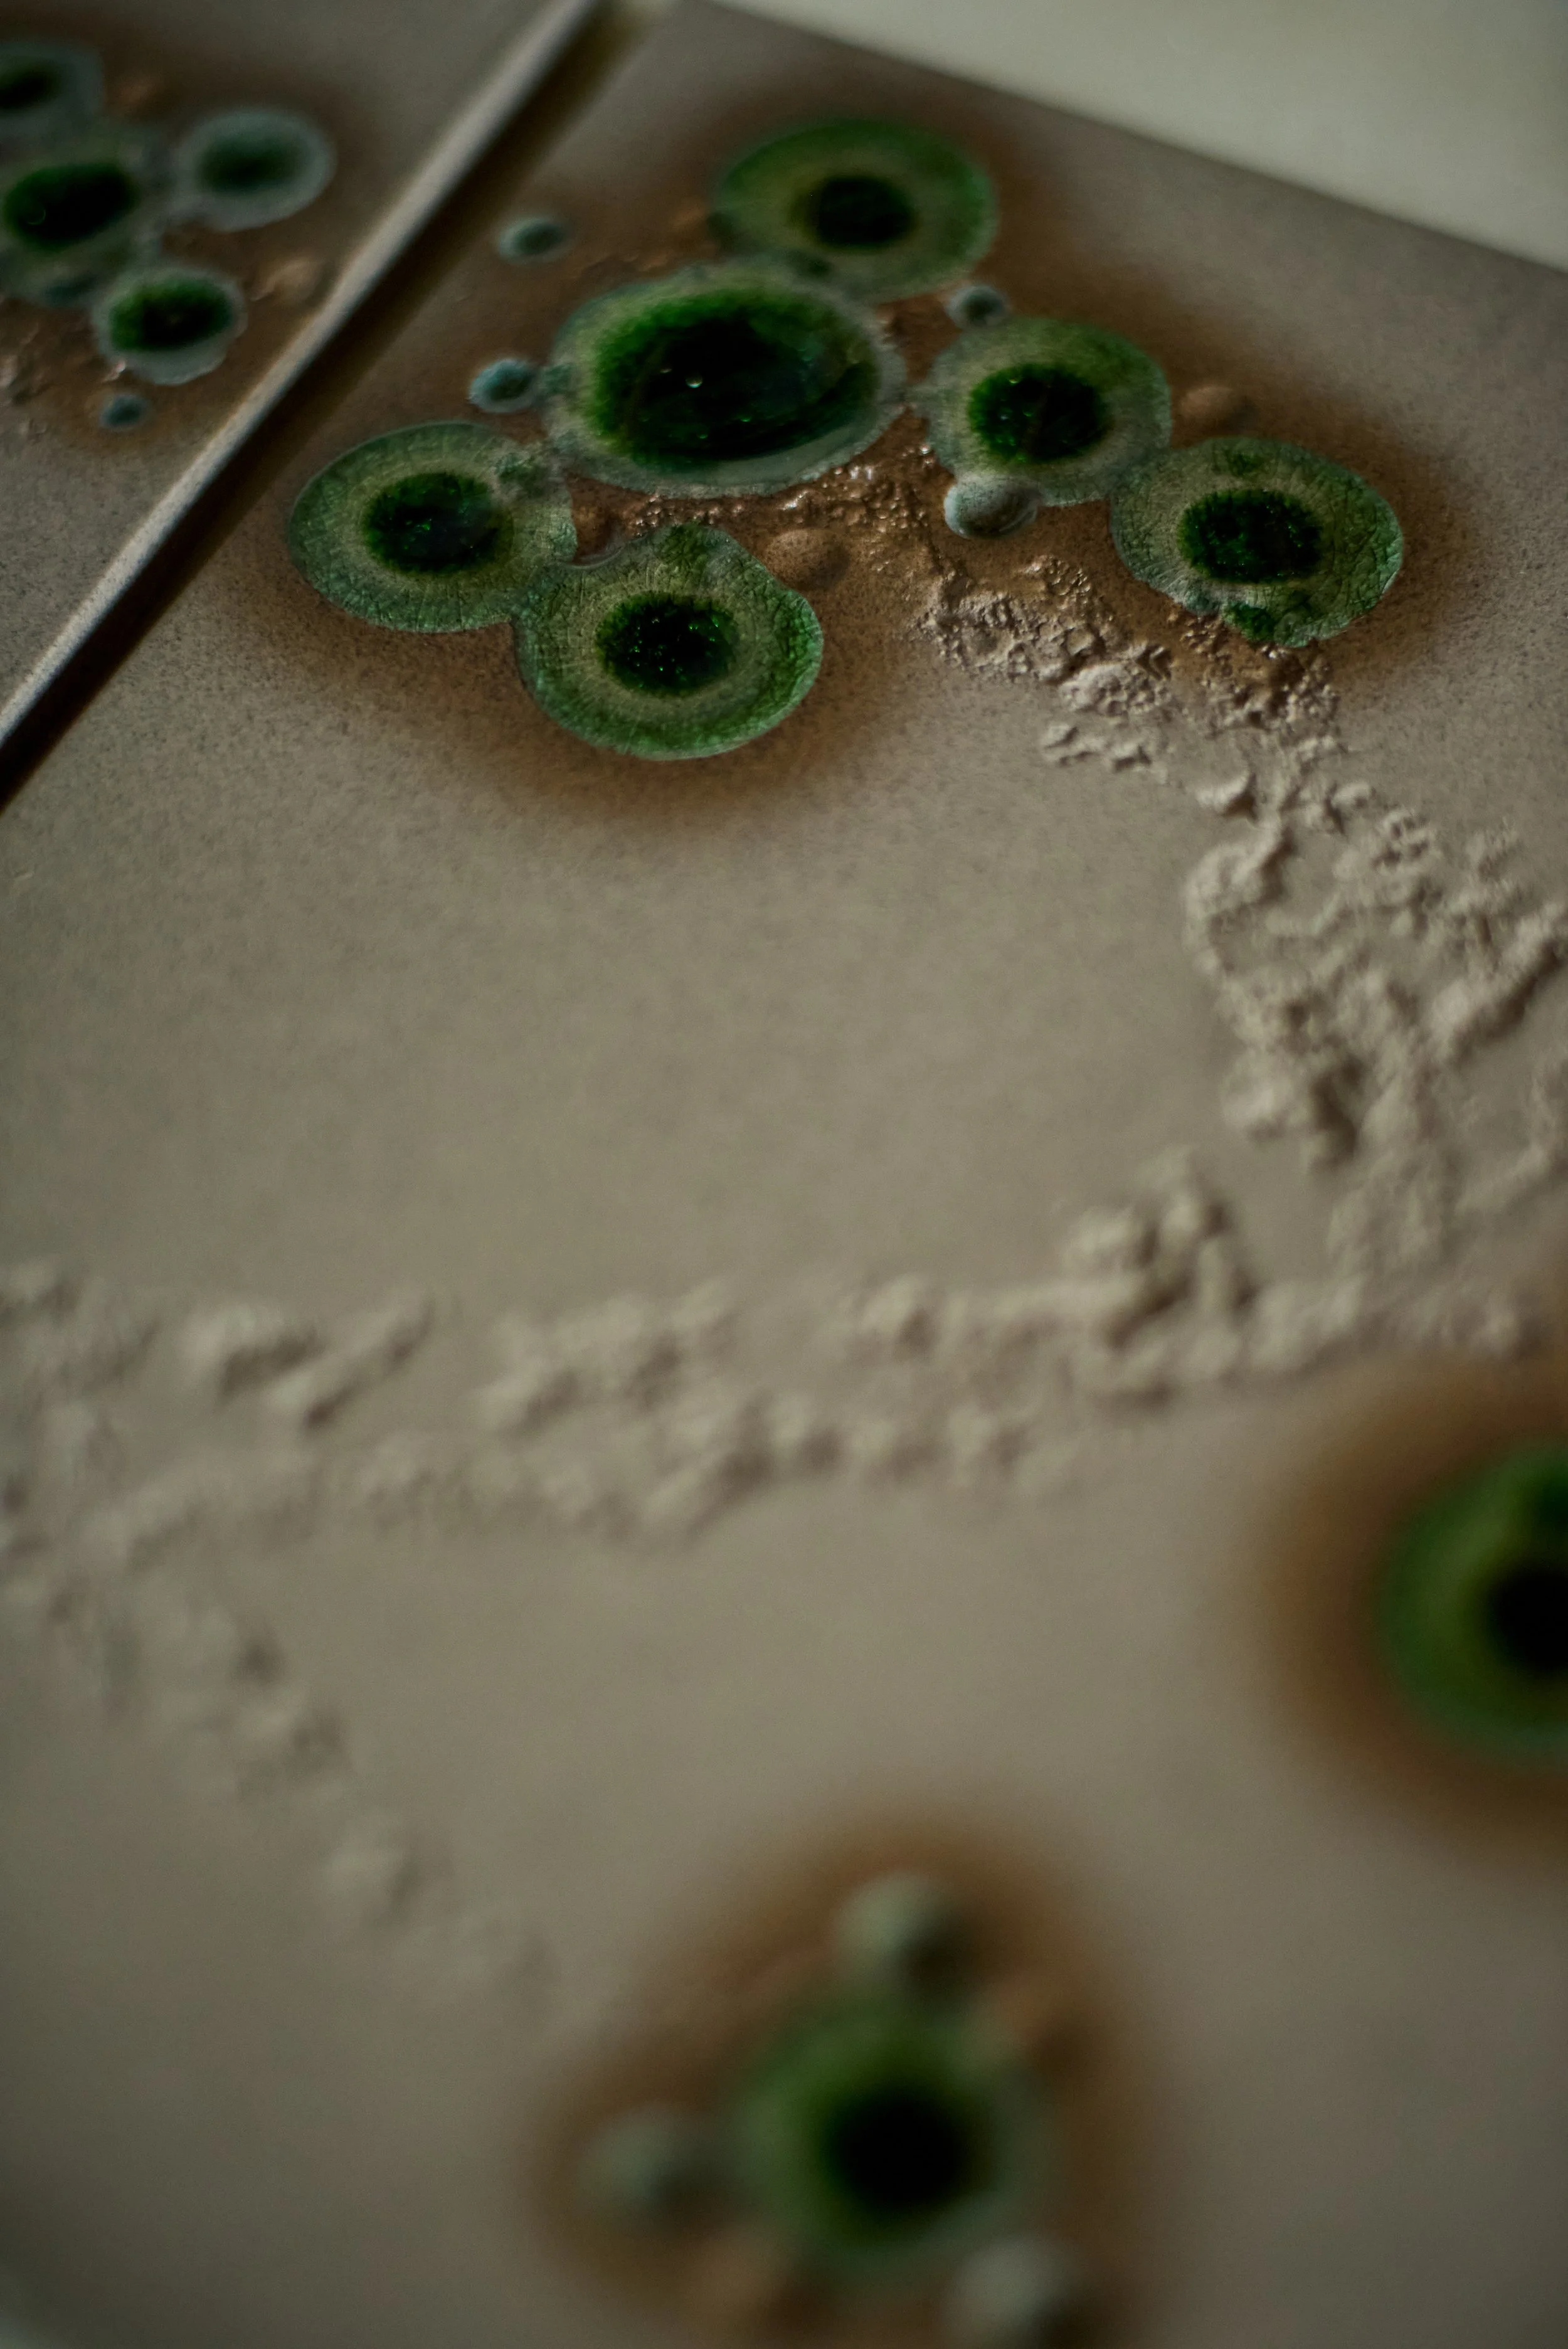
Close-up of mold colonies on a Teflon-coated surface, showing green circular growths with darker centers and some white powdery residue.

The Artist
Self-Introduction

Welcome to my refuge — my temple and gate to my inner world. I am the Artifact Maker, and this is my soul’s path.
As a child I was deeply fascinated with myth, symbolism and stories about magic. Fittingly, when first asked what I wanted to become, I said a priest. My ceramic work is the closest I’ve come to following those callings.
Through serendipity and after a rough skirmish with my rational side, I’ve eventually found my own connection to something higher than the self. Now years later, I lend my hands to that…
Finding the Path of Clay

I came to ceramics through chance encounters, long periods of uncertainty, and a growing but unbeknown need to center my life around creation.
During my stay in Japan I encountered ceramics through tea ceremonies, museum visits, and everyday encounters, yet at the time, it felt like just one of many impressions. Years later, back in Germany and in a difficult phase of my life, I encountered a ceramic artist and her work deeply touched me. During my first day of internship in her studio, I knew I’ve touched something.
That “something” I still can’t quite catch with words, but it’s an equal sense of longing and arrival, a connection beautiful and difficult to tend to … for the lack of a better expression, I call it “the Path of Clay”.
Devotion

Devotion to the craft means showing up again and again. Listening to the material, working slowly, and accepting that not everything can be controlled.
It also means embracing imperfections as part of life itself — something ceramics reflects so clearly. Each piece carries marks and weak spots, a reminder that beauty can only emerge when resistance fades and acceptance takes its place.
Dreaming

Much of what shapes my pieces happens away from the studio, in quiet moments of stillness where I allow myself to drift, observe, and imagine. This slower, more inward way of working feeds the making process, creating space for possibilities to reveal themselves before I step into work.
The Process

The process is not a straight line. It begins with an idea or a feeling, but more than anything it is a dialogue between soul and material. I follow what it shows me, adjusting, refining, and sometimes surrendering.
Some pieces seem to spring into existence almost fully formed, as if they only needed my hands to arrive. Others linger - resting for months or even years, waiting until the right moment reveals how they can be finished.
Sometimes the process is smooth and quick, other times it is slow and difficult — but it is always rooted in presence and attention. The final piece is not a fixed outcome, but the result of listening and responding.

The Studio

